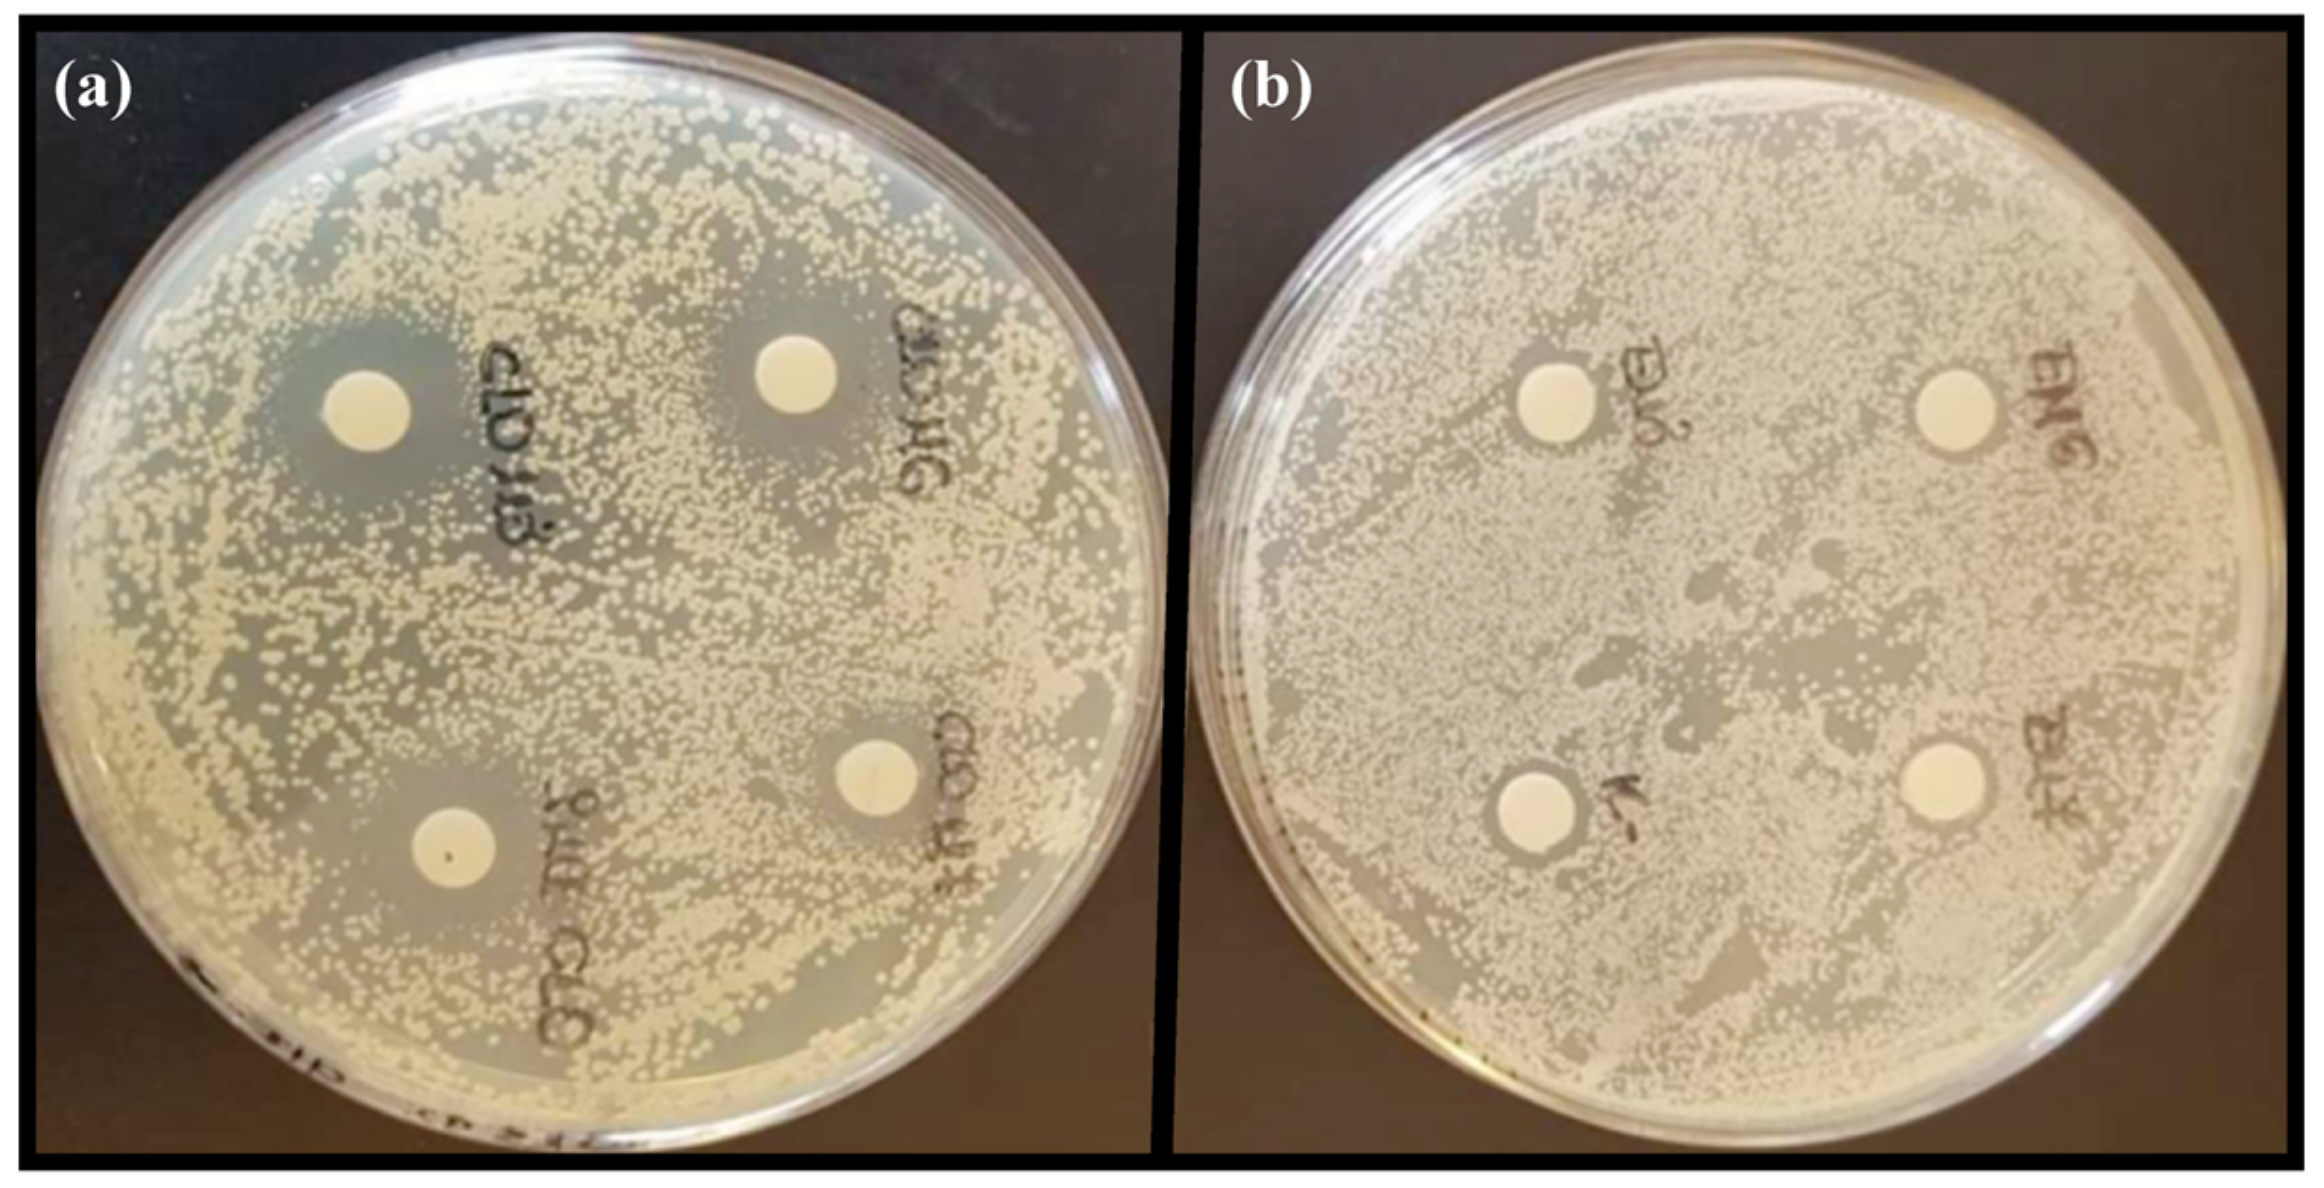

Lecithin and Chitosan as Building Blocks in Anti-Candida Clotrimazole Nanoparticles
Abstract
1. Introduction
2. Results and Discussion
2.1. Nanoparticle Development
2.2. Nanoparticle Characteristics
2.3. Nanoparticle Stability
2.4. Evaluation of Toxicity
2.5. Anti-Candida Activity
3. Materials and Methods
3.1. Materials
3.2. Nanoparticle Preparation
3.3. Characterisation of Nanoparticles
3.3.1. Size, Zeta Potential, and pH Determination
3.3.2. CLO-LCN Morphology
3.3.3. Nanoparticle Stability
3.4. Toxicity Evaluation
3.5. Anti-Candida Evaluation
3.5.1. Anti-Candida Activity Determined as Zone of Inhibition
3.5.2. Anti-Candida Activity Determined through Broth Microdilution
3.6. Statistical Analyses
4. Conclusions
Author Contributions
Funding
Institutional Review Board Statement
Informed Consent Statement
Data Availability Statement
Acknowledgments
Conflicts of Interest
References
- Sen, C.K. Human Wound and Its Burden: Updated 2020 Compendium of Estimates. Adv. Wound Care 2021, 10, 281–292. [Google Scholar] [CrossRef]
- Xu, Z.; Hsia, H.C. The Impact of Microbial Communities on Wound Healing: A Review. Ann. Plast. Surg. 2018, 81, 113–123. [Google Scholar] [CrossRef] [PubMed]
- Kalan, L.; Grice, E.A. Fungi in the Wound Microbiome. Adv. Wound Care 2017, 7, 247–255. [Google Scholar] [CrossRef] [PubMed]
- Kalan, L.; Loesche, M.; Brendan, P.H.; Heilmann, K.; Ruthel, G.; Gardner Sue, E.; Grice Elizabeth, A. Redefining the Chronic-Wound Microbiome: Fungal Communities Are Prevalent, Dynamic, and Associated with Delayed Healing. mBio 2016, 7, e01058-16. [Google Scholar] [CrossRef] [PubMed]
- Dowd, S.E.; Delton Hanson, J.; Rees, E.; Wolcott, R.D.; Zischau, A.M.; Sun, Y.; White, J.; Smith, D.M.; Kennedy, J.; Jones, C.E. Survey of fungi and yeast in polymicrobial infections in chronic wounds. J. Wound Care 2011, 20, 40–47. [Google Scholar] [CrossRef] [PubMed]
- Gil, J.; Solis, M.; Higa, A.; Davis, S.C. Candida albicans Infections: A novel porcine wound model to evaluate treatment efficacy. BMC Microbiol. 2022, 22, 45. [Google Scholar] [CrossRef] [PubMed]
- Ibberson, C.B.; Whiteley, M. The social life of microbes in chronic infection. Curr. Opin. Microbiol. 2020, 53, 44–50. [Google Scholar] [CrossRef]
- Krüger, W.; Vielreicher, S.; Kapitan, M.; Jacobsen, I.D.; Niemiec, M.J. Fungal-Bacterial Interactions in Health and Disease. Pathogens 2019, 8, 70. [Google Scholar] [CrossRef]
- Bolla, P.K.; Meraz, C.A.; Rodriguez, V.A.; Deaguero, I.; Singh, M.; Yellepeddi, V.K.; Renukuntla, J. Clotrimazole Loaded Ufosomes for Topical Delivery: Formulation Development and In-Vitro Studies. Molecules 2019, 24, 3139. [Google Scholar] [CrossRef]
- Mendling, W.; Atef El Shazly, M.; Zhang, L. Clotrimazole for Vulvovaginal Candidosis: More Than 45 Years of Clinical Experience. Pharmaceuticals 2020, 13, 274. [Google Scholar] [CrossRef]
- Crowley, P.D.; Gallagher, H.C. Clotrimazole as a pharmaceutical: Past, present and future. J. Appl. Microbiol. 2014, 117, 611–617. [Google Scholar] [CrossRef] [PubMed]
- Taudorf, E.H.; Jemec, G.B.E.; Hay, R.J.; Saunte, D.M.L. Cutaneous candidiasis—An evidence-based review of topical and systemic treatments to inform clinical practice. J. Eur. Acad. Dermatol. Venereol. 2019, 33, 1863–1873. [Google Scholar] [CrossRef] [PubMed]
- Sousa, F.; Ferreira, D.; Reis, S.; Costa, P. Current Insights on Antifungal Therapy: Novel Nanotechnology Approaches for Drug Delivery Systems and New Drugs from Natural Sources. Pharmaceuticals 2020, 13, 248. [Google Scholar] [CrossRef] [PubMed]
- Ma, M.; Wang, J.; Yang, X.; Qu, Y. Solubility and Thermodynamic Properties of Clotrimazole in 16 Organic Solvents at Temperature of 283.15 to 323.15 K. J. Chem. Eng. Data 2023, 68, 698–711. [Google Scholar] [CrossRef]
- Kane, A.; Carter, D.A. Augmenting Azoles with Drug Synergy to Expand the Antifungal Toolbox. Pharmaceuticals 2022, 15, 482. [Google Scholar] [CrossRef] [PubMed]
- Carbone, C.; Fuochi, V.; Zielińska, A.; Musumeci, T.; Souto, E.B.; Bonaccorso, A.; Puglia, C.; Petronio Petronio, G.; Furneri, P.M. Dual-drugs delivery in solid lipid nanoparticles for the treatment of Candida albicans mycosis. Colloids Surf. B 2020, 186, 110705. [Google Scholar] [CrossRef]
- Carbone, C.; Teixeira, M.d.C.; Sousa, M.d.C.; Martins-Gomes, C.; Silva, A.M.; Souto, E.M.B.; Musumeci, T. Clotrimazole-Loaded Mediterranean Essential Oils NLC: A Synergic Treatment of Candida Skin Infections. Pharmaceutics 2019, 11, 231. [Google Scholar] [CrossRef]
- Souto, E.B.; Müller, R.H. The use of SLN® and NLC® as topical particulate carriers for imidazole antifungal agents. Pharmazie 2006, 61, 431–437. [Google Scholar]
- Souto, E.B.; Müller, R.H. Rheological and in vitro release behaviour of clotrimazole-containing aqueous SLN dispersions and commercial creams. Pharmazie 2007, 62, 505–509. [Google Scholar] [CrossRef]
- Andersen, T.; Mishchenko, E.; Flaten, G.E.; Sollid, J.U.E.; Mattsson, S.; Tho, I.; Škalko-Basnet, N. Chitosan-Based Nanomedicine to Fight Genital Candida Infections: Chitosomes. Mar. Drugs 2017, 15, 64. [Google Scholar] [CrossRef]
- Giordani, B.; Basnet, P.; Mishchenko, E.; Luppi, B.; Škalko-Basnet, N. Utilizing Liposomal Quercetin and Gallic Acid in Localized Treatment of Vaginal Candida Infections. Pharmaceutics 2019, 12, 9. [Google Scholar] [CrossRef] [PubMed]
- Ke, C.-L.; Deng, F.-S.; Chuang, C.-Y.; Lin, C.-H. Antimicrobial Actions and Applications of Chitosan. Polymers 2021, 13, 904. [Google Scholar] [CrossRef] [PubMed]
- Elshaer, E.E.; Elwakil, B.H.; Eskandrani, A.; Elshewemi, S.S.; Olama, Z.A. Novel Clotrimazole and Vitis vinifera loaded chitosan nanoparticles: Antifungal and wound healing efficiencies. Saudi J. Biol. Sci. 2022, 29, 1832–1841. [Google Scholar] [CrossRef] [PubMed]
- Kraegeloh, A.; Suarez-Merino, B.; Sluijters, T.; Micheletti, C. Implementation of Safe-by-Design for Nanomaterial Development and Safe Innovation: Why We Need a Comprehensive Approach. Nanomaterials 2018, 8, 239. [Google Scholar] [CrossRef] [PubMed]
- Wang, L.; Hu, C.; Shao, L. The antimicrobial activity of nanoparticles: Present situation and prospects for the future. Int. J. Nanomed. 2017, 2017, 1227–1249. [Google Scholar] [CrossRef]
- Chhonker, Y.S.; Prasad, Y.D.; Chandasana, H.; Vishvkarma, A.; Mitra, K.; Shukla, P.K.; Bhatta, R.S. Amphotericin-B entrapped lecithin/chitosan nanoparticles for prolonged ocular application. Int. J. Biol. Macromol. 2015, 72, 1451–1458. [Google Scholar] [CrossRef]
- Sonvico, F.; Cagnani, A.; Rossi, A.; Motta, S.; Di Bari, M.T.; Cavatorta, F.; Alonso, M.J.; Deriu, A.; Colombo, P. Formation of self-organized nanoparticles by lecithin/chitosan ionic interaction. Int. J. Pharm. 2006, 324, 67–73. [Google Scholar] [CrossRef]
- Bugnicourt, L.; Ladavière, C. A close collaboration of chitosan with lipid colloidal carriers for drug delivery applications. J. Control. Release 2017, 256, 121–140. [Google Scholar] [CrossRef]
- Manca, M.L.; Usach, I.; Peris, J.E.; Ibba, A.; Orrù, G.; Valenti, D.; Escribano-Ferrer, E.; Gomez-Fernandez, J.C.; Aranda, F.J.; Fadda, A.M.; et al. Optimization of Innovative Three-Dimensionally-Structured Hybrid Vesicles to Improve the Cutaneous Delivery of Clotrimazole for the Treatment of Topical Candidiasis. Pharmaceutics 2019, 11, 263. [Google Scholar] [CrossRef]
- Bhardwaj, V.; Monga, J.; Sharma, A.; Sharma, S.; Sharma, A.; Sharma, P. A novel surfactant aided micellar system of oxidation inhibitors in clotrimazole bioadhesive gel: Development, characterization, in vitro and in vivo antifungal evaluation against Candida clinical isolates. RSC Adv. 2014, 4, 47207–47221. [Google Scholar] [CrossRef]
- Bouz, G.; Doležal, M. Advances in Antifungal Drug Development: An Up-To-Date Mini Review. Pharmaceuticals 2021, 14, 1312. [Google Scholar] [CrossRef]
- Gupta, A.K.; Venkataraman, M.; Renaud, H.J.; Summerbell, R.; Shear, N.H.; Piguet, V. The increasing problem of treatment-resistant fungal infections: A call for antifungal stewardship programs. Int. J. Dermatol. 2021, 60, e474–e479. [Google Scholar] [CrossRef] [PubMed]
- Nene, S.; Shah, S.; Rangaraj, N.; Mehra, N.K.; Singh, P.K.; Srivastava, S. Lipid based nanocarriers: A novel paradigm for topical antifungal therapy. J. Drug Deliv. Sci. Technol. 2021, 62, 102397. [Google Scholar] [CrossRef]
- Du, W.; Gao, Y.; Liu, L.; Sai, S.; Ding, C. Striking Back against Fungal Infections: The Utilization of Nanosystems for Antifungal Strategies. Int. J. Mol. Sci. 2021, 22, 10104. [Google Scholar] [CrossRef]
- Drummond, D.C.; Noble, C.O.; Hayes, M.E.; Park, J.W.; Kirpotin, D.B. Pharmacokinetics and in vivo drug release rates in liposomal nanocarrier development. J. Pharm. Sci. 2008, 97, 4696–4740. [Google Scholar] [CrossRef] [PubMed]
- Jøraholmen, M.W.; Vanić, Ž.; Tho, I.; Škalko-Basnet, N. Chitosan-coated liposomes for topical vaginal therapy: Assuring localized drug effect. Int. J. Pharm. 2014, 472, 94–101. [Google Scholar] [CrossRef]
- Blažević, F.; Milekić, T.; Romić, M.D.; Juretić, M.; Pepić, I.; Filipović-Grčić, J.; Lovrić, J.; Hafner, A. Nanoparticle-mediated interplay of chitosan and melatonin for improved wound epithelialisation. Carbohydr. Polym. 2016, 146, 445–454. [Google Scholar] [CrossRef]
- Ing, L.Y.; Zin, N.M.; Sarwar, A.; Katas, H. Antifungal Activity of Chitosan Nanoparticles and Correlation with Their Physical Properties. Int. J. Biomater. 2012, 2012, 632698. [Google Scholar] [CrossRef]
- Tayel, A.A.; Moussa, S.; El-Tras, W.F.; Knittel, D.; Opwis, K.; Schollmeyer, E. Anticandidal action of fungal chitosan against Candida albicans. Int. J. Biol. Macromol. 2010, 47, 454–457. [Google Scholar] [CrossRef]
- Souto, E.B.; Wissing, S.A.; Barbosa, C.M.; Müller, R.H. Development of a controlled release formulation based on SLN and NLC for topical clotrimazole delivery. Int. J. Pharm. 2004, 278, 71–77. [Google Scholar] [CrossRef]
- Clementino, A.; Batger, M.; Garrastazu, G.; Pozzoli, M.; Del Favero, E.; Rondelli, V.; Gutfilen, B.; Barboza, T.; Sukkar, M.B.; Souza, S.A.; et al. The nasal delivery of nanoencapsulated statins—An approach for brain delivery. Int. J. Nanomed. 2016, 11, 6575–6590. [Google Scholar] [CrossRef] [PubMed]
- Kurlyandskaya, G.V.; Litvinova, L.S.; Safronov, A.P.; Schupletsova, V.V.; Tyukova, I.S.; Khaziakhmatova, O.G.; Slepchenko, G.B.; Yurova, K.A.; Cherempey, E.G.; Kulesh, N.A.; et al. Water-Based Suspensions of Iron Oxide Nanoparticles with Electrostatic or Steric Stabilization by Chitosan: Fabrication, Characterization and Biocompatibility. Sensors 2017, 17, 2605. [Google Scholar] [CrossRef] [PubMed]
- Fromtling, R.A. Overview of medically important antifungal azole derivatives. Clin. Microbiol. Rev. 1988, 1, 187–217. [Google Scholar] [CrossRef]
- Patel, V.; Sharma, O.P.; Mehta, T.A. Impact of Process Parameters on Particle Size Involved in Media Milling Technique Used for Preparing Clotrimazole Nanocrystals for the Management of Cutaneous Candidiasis. AAPS PharmSciTech 2019, 20, 175. [Google Scholar] [CrossRef] [PubMed]
- Hafner, A.; Lovrić, J.; Pepić, I.; Filipović-Grčić, J. Lecithin/chitosan nanoparticles for transdermal delivery of melatonin. J. Microencapsul. 2011, 28, 807–815. [Google Scholar] [CrossRef] [PubMed]
- ISO 10993-5:2009; Biological Evaluation of Medical Devices–Part 5: Tests for in Vitro Cytotoxicity. International Organization for Standardization ISO: Geneva, Switzerland, 2009.
- Rizeq, B.R.; Younes, N.N.; Rasool, K.; Nasrallah, G.K. Synthesis, Bioapplications, and Toxicity Evaluation of Chitosan-Based Nanoparticles. Int. J. Mol. Sci. 2019, 20, 5776. [Google Scholar] [CrossRef]
- Johnson, W.; Bergfeld, W.F.; Belsito, D.V.; Hill, R.A.; Klaassen, C.D.; Liebler, D.C.; Marks, J.G.; Shank, R.C.; Slaga, T.J.; Snyder, P.W.; et al. Safety Assessment of Lecithin and Other Phosphoglycerides as Used in Cosmetics. Int. J. Toxicol. 2020, 39, 5S–25S. [Google Scholar] [CrossRef]
- Hemmingsen, L.M.; Panchai, P.; Julin, K.; Basnet, P.; Nystad, M.; Johannessen, M.; Škalko-Basnet, N. Chitosan-based delivery system enhances antimicrobial activity of chlorhexidine. Front. Microbiol. 2022, 13, 1023083. [Google Scholar] [CrossRef]
- Ternullo, S.; Gagnat, E.; Julin, K.; Johannessen, M.; Basnet, P.; Vanić, Ž.; Škalko-Basnet, N. Liposomes augment biological benefits of curcumin for multitargeted skin therapy. Eur. J. Pharm. Biopharm. 2019, 144, 154–164. [Google Scholar] [CrossRef]
- Hemmingsen, L.M.; Škalko-Basnet, N.; Jøraholmen, M.W. The Expanded Role of Chitosan in Localized Antimicrobial Therapy. Mar. Drugs 2021, 19, 697. [Google Scholar] [CrossRef]
- Valencia, M.S.; Franco da Silva Júnior, M.; Xavier Júnior, F.H.; de Oliveira Veras, B.; Fernanda de Oliveira Borba, E.; Gonçalves da Silva, T.; Xavier, V.L.; Pessoa de Souza, M.; Carneiro-da-Cunha, M.d.G. Bioactivity and cytotoxicity of quercetin-loaded, lecithin-chitosan nanoparticles. Biocatal. Agric. Biotechnol. 2021, 31, 101879. [Google Scholar] [CrossRef]
- Valencia, M.S.; Silva Júnior, M.F.d.; Xavier-Júnior, F.H.; Veras, B.d.O.; Albuquerque, P.B.S.d.; Borba, E.F.d.O.; Silva, T.G.d.; Xavier, V.L.; Souza, M.P.d.; Carneiro-da-Cunha, M.d.G. Characterization of curcumin-loaded lecithin-chitosan bioactive nanoparticles. Carbohydr. Polym. Technol. Appl. 2021, 2, 100119. [Google Scholar] [CrossRef]
- Poznanski, P.; Hameed, A.; Orczyk, W. Chitosan and Chitosan Nanoparticles: Parameters Enhancing Antifungal Activity. Molecules 2023, 28, 2996. [Google Scholar] [CrossRef]
- Schulte-Werning, L.V.; Murugaiah, A.; Singh, B.; Johannessen, M.; Engstad, R.E.; Škalko-Basnet, N.; Holsæter, A.M. Multifunctional Nanofibrous Dressing with Antimicrobial and Anti-Inflammatory Properties Prepared by Needle-Free Electrospinning. Pharmaceutics 2021, 13, 1527. [Google Scholar] [CrossRef] [PubMed]
- Parolin, C.; Marangoni, A.; Laghi, L.; Foschi, C.; Ñahui Palomino, R.A.; Calonghi, N.; Cevenini, R.; Vitali, B. Isolation of Vaginal Lactobacilli and Characterization of Anti-Candida Activity. PLoS ONE 2015, 10, e0131220. [Google Scholar] [CrossRef]
- Hemmingsen, L.M.; Giordani, B.; Pettersen, A.K.; Vitali, B.; Basnet, P.; Škalko-Basnet, N. Liposomes-in-chitosan hydrogel boosts potential of chlorhexidine in biofilm eradication in vitro. Carbohydr. Polym. 2021, 262, 117939. [Google Scholar] [CrossRef]
- Obuobi, S.; Julin, K.; Fredheim, E.G.A.; Johannessen, M.; Škalko-Basnet, N. Liposomal delivery of antibiotic loaded nucleic acid nanogels with enhanced drug loading and synergistic anti-inflammatory activity against S. aureus intracellular infections. J. Control. Release 2020, 324, 620–632. [Google Scholar] [CrossRef]
- Abruzzo, A.; Bigucci, F.; Cerchiara, T.; Cruciani, F.; Vitali, B.; Luppi, B. Mucoadhesive chitosan/gelatin films for buccal delivery of propranolol hydrochloride. Carbohydr. Polym. 2012, 87, 581–588. [Google Scholar] [CrossRef]

| Size 1 (≥75%, nm) | PI 2 | Zeta Potential (mV) | EE% 3 | pH | |
|---|---|---|---|---|---|
| LCNs | 350 ± 47 | 0.26 ± 0.01 | 31.7 ± 4.0 | - | 4.19 ± 0.07 |
| CLO-LCNs | 189 ± 24 | 0.28 ± 0.07 | 24.3 ± 4.0 | 14.7 ± 2.5 | 4.39 ± 0.11 |
| Zone of Inhibition | |||
|---|---|---|---|
| LCNs | Free CLO | CLO-LCNs | |
| C. albicans SO1 | N.I. | 4.12 ± 0.37 | 3.83 ± 0.44 |
| C. albicans SO2 | N.I. | 7.06 ± 0.57 | 6.79 ± 0.40 |
| LCN | CLO-LCNs | |
|---|---|---|
| Chitosan/lecithin ratio | 1:20 | 1:20 |
| CLO | - | 0.82 mg/mL |
Disclaimer/Publisher’s Note: The statements, opinions and data contained in all publications are solely those of the individual author(s) and contributor(s) and not of MDPI and/or the editor(s). MDPI and/or the editor(s) disclaim responsibility for any injury to people or property resulting from any ideas, methods, instructions or products referred to in the content. |
© 2023 by the authors. Licensee MDPI, Basel, Switzerland. This article is an open access article distributed under the terms and conditions of the Creative Commons Attribution (CC BY) license (https://creativecommons.org/licenses/by/4.0/).
Share and Cite
Hemmingsen, L.M.; Panzacchi, V.; Kangu, L.M.; Giordani, B.; Luppi, B.; Škalko-Basnet, N. Lecithin and Chitosan as Building Blocks in Anti-Candida Clotrimazole Nanoparticles. Pharmaceuticals 2023, 16, 790. https://doi.org/10.3390/ph16060790
Hemmingsen LM, Panzacchi V, Kangu LM, Giordani B, Luppi B, Škalko-Basnet N. Lecithin and Chitosan as Building Blocks in Anti-Candida Clotrimazole Nanoparticles. Pharmaceuticals. 2023; 16(6):790. https://doi.org/10.3390/ph16060790
Chicago/Turabian StyleHemmingsen, Lisa Myrseth, Virginia Panzacchi, Lloyd Mbugua Kangu, Barbara Giordani, Barbara Luppi, and Nataša Škalko-Basnet. 2023. "Lecithin and Chitosan as Building Blocks in Anti-Candida Clotrimazole Nanoparticles" Pharmaceuticals 16, no. 6: 790. https://doi.org/10.3390/ph16060790
APA StyleHemmingsen, L. M., Panzacchi, V., Kangu, L. M., Giordani, B., Luppi, B., & Škalko-Basnet, N. (2023). Lecithin and Chitosan as Building Blocks in Anti-Candida Clotrimazole Nanoparticles. Pharmaceuticals, 16(6), 790. https://doi.org/10.3390/ph16060790

